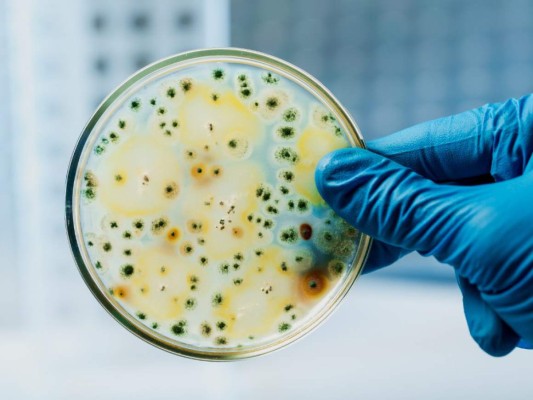
¿Qué es el cólera y cómo debemos cuidarnos los hondureños?

“Se realizarán muestras de heces, se analizarán mediante laboratorios las fuentes de aguas de centros turísticos y recreativos de la zona”, aseguró la ministra.
Aunque aún no se han detectado casos en personas, sí se conformó un cerco epidemiológico con un plan de acción. ¿Pero qué es el cólera? A continuación te explicamos.
Según la Organización Mundial de la Salud (OMS), el cólera es una infección intestinal aguda causada por la ingestión de alimentos o agua contaminados por la bacteria Vibrio cholerae.
Tiene un período de incubación corto, entre menos de un día y cinco días, y la bacteria produce una enterotoxina que causa una diarrea copiosa, indolora y acuosa que puede conducir con rapidez a una deshidratación grave y a la muerte si no se trata prontamente. La mayor parte de los pacientes sufren vómitos.
¿Cuáles son los síntomas?
La mayoría de las personas infectadas por no presentan síntomas, aunque la bacteria esté presente en sus heces durante los 1 a 10 días siguientes a la infección. En el 80% de las personas que presentan síntomas, son de leves a moderados; un 20% padece diarrea acuosa aguda con deshidratación grave. Si no se da tratamiento, esta puede ocasionar la muerte.Las personas con inmunidad reducida corren un riesgo mayor de morir si se infectan.
Otros datos
1. El cólera mata cada año entre 21,000 y 143,000 personas, según la OMS.2. Hasta un 80% de los casos pueden tratarse efizcamente con sales de rehidatración oral.
3. Las bacterias eliminadas con las heces vuelven al medio ambiente y pueden infectar a otras personas si no se aplican efectivas medidas de saneamiento.
Prevención
1. Evitar el consumo de frutas y vegetales crudos.2. Evitar los restaurantes en los que es evidente que no se siguen las recomendaciones habituales de higiene en la manipulación, preparación y conservación de los alimentos.
3. Beber solo agua purificada, abierta por uno mismo.
4. Lavar bien las manos con agua y jabón al manipular y preparar alimentos, antes de comer y después de ir al baño o mudar lactantes.